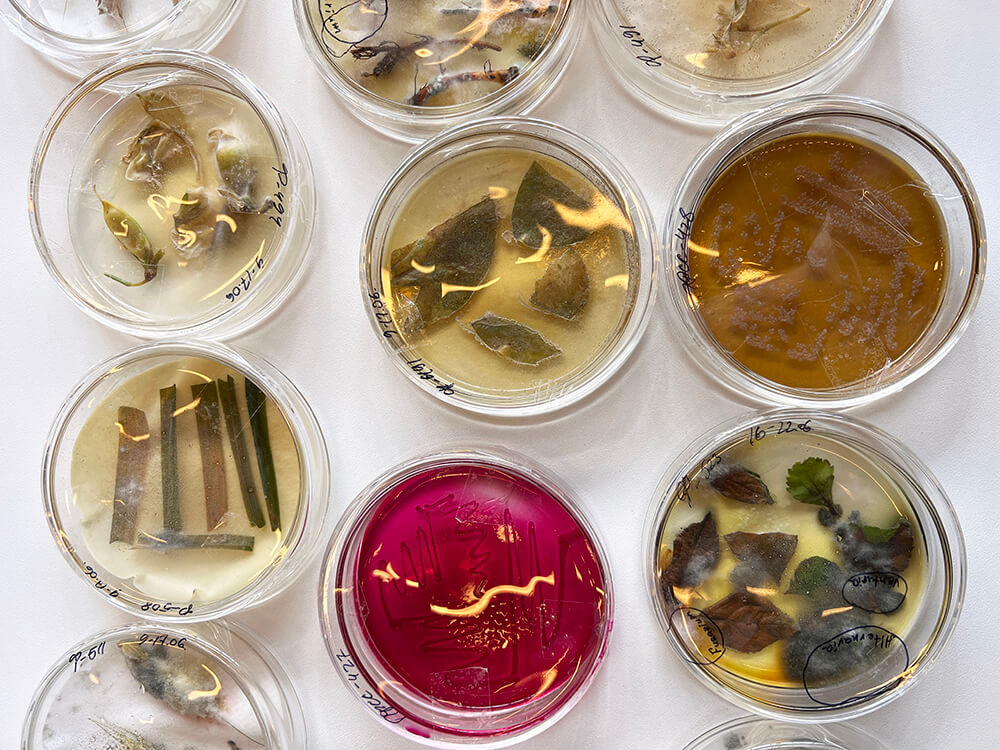

23-июндан 25-июнга чейин Ставрополь крайынын минералдык суулары шаарында "Минсууэкспо" көргөзмө комплексинде багбандар үчүн "РгоЯблоко-2022"конгресс-көргөзмөсү өтүүдө. Бул жерде ата мекендик жана чет элдик мөмө-жемиш тармагынын адистери чогулушту.
"Август" стендинде көргөзмөнүн конокторуна компаниянын технологдору ар кайсы аймактардан кеңеш беришет: Тим Акимов (Ставрополь крайы), Светлана Кононенко (Краснодар крайы), Иван Харитонов (Тамбов облусу). Бул жерде "Августа" Ставрополь агроабораториясынын жетекчиси Михаил Супруненко жана башка адистер диагностикалык борбордун мүмкүнчүлүктөрү жөнүндө айтып беришет.
Сизди хоч 86 компаниясынын стендиндеги көргөзмөдө күтөбүз!